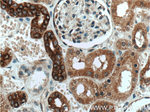
AMFR Antibody in Immunohistochemistry (Paraffin) (IHC (P))

Search
Proteintech
AMFR Polyclonal Antibody
{{$productOrderCtrl.translations['antibody.pdp.commerceCard.promotion.promotions']}}
{{$productOrderCtrl.translations['antibody.pdp.commerceCard.promotion.viewpromo']}}
{{$productOrderCtrl.translations['antibody.pdp.commerceCard.promotion.promocode']}}: {{promo.promoCode}} {{promo.promoTitle}} {{promo.promoDescription}}. {{$productOrderCtrl.translations['antibody.pdp.commerceCard.promotion.learnmore']}}
产品信息
16675-1-AP
种属反应
已发表种属
宿主/亚型
分类
类型
抗原
偶联物
形式
浓度
规格
纯化类型
保存液
内含物
保存条件
运输条件
产品详细信息
Immunogen sequence: LFHEVQRRI RRHKNYLRVV GNMEARFAVA TPEELAVNND DCAICWDSMQ AARKLPCGHL FHNSCLRSWL EQDTSCPTCR MSLNIADNNR VREEHQGENL DENLVPVAAA EGRPRLNQHN HFFHFDGSRI ASWLPSFSVE VMHTTNILGI TQASNSQLNA MAHQIQEMFP QVPYHLVLQD LQLTRSVEIT TDNILEGRIQ VPFPTQRSDS IRPALNSPVE RPSSDQEEGE TSAQTERVPL DLSPRLEETL DFGEVEVEPS EVEDFEARGS RFSKSADERQ RMLVQRKDEL LQQARKRFLN KSSEDDAASE SFLPSEGASS DPVTLRRRML AAAAERRLQK QQTS (301-643 aa encoded by B C069197)
靶标信息
Autocrine motility factor is a tumor motility-stimulating protein secreted by tumor cells. The protein encoded by this gene is a glycosylated transmembrane protein and a receptor for autocrine motility factor. The receptor, which shows some sequence similarity to tumor protein p53, is localized to the leading and trailing edges of carcinoma cells.
仅用于科研。不用于诊断过程。未经明确授权不得转售。
生物信息学
蛋白别名: AMF receptor; Autocrine motility factor receptor; autocrine motility factor receptor, E3 ubiquitin protein ligase; E3 ubiquitin-protein ligase AMFR; gp78; RING finger protein 45; RING-type E3 ubiquitin transferase AMFR
基因别名: AMFR; GP78; RNF45; SPG89
UniProt ID: (Human) Q9UKV5, (Mouse) Q9R049
Entrez Gene ID: (Human) 267, (Rat) 361367, (Mouse) 23802